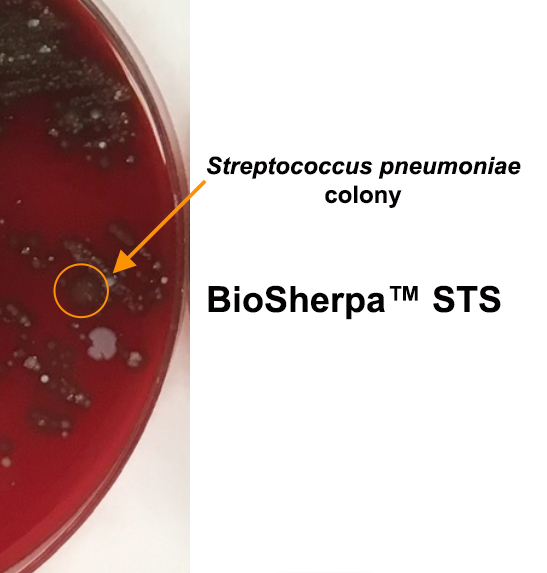

BioSherpa™ STS diagnosed Streptococcus pneumoniae despite 2 days of effective antibiotics
BioSherpa
™ STS
cultured S. pneumoniae despite 2 days of antibiotics
Only BioSherpa™ STS revealed S. pneumoniae as the causative pathogen whereas standard collection methods yielded only normal flora.
Streptococcus pneumoniae
This patient had a positive S. pneumoniae urine antigen. This test indicates that the patient suffered from an invasive infection that wasn’t detected with standard sputum or blood cultures. Previous to the initial test, antibiotics had been started for sepsis and had killed the causative pathogen in the standard sputum culture. When BioSherpa™ STS was used, it was able to release the causative pathogen from its protective biofilm for a proper diagnosis.
Streptococcus pneumoniae subcultured and proven.
BioSherpa™ STS was able to prove that there was still active and infectious S. pneumoniae after the patient was on antibiotics for two days.